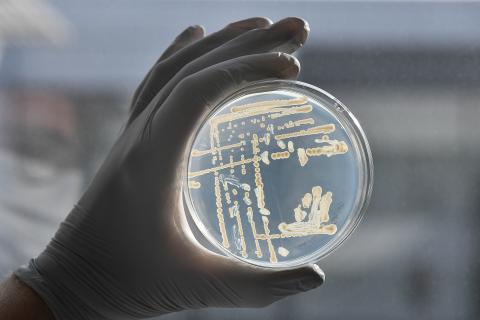

Offre
10 février 2025Le Biotech’InnLab offre un accompagnement sur-mesure, en s’appuyant sur des compétences scientifiques et techniques de haut niveau pour répondre aux besoins spécifiques de chaque projet. Cet espace dynamique et collaboratif permet aux entrepreneurs de concrétiser leurs idées tout en s’intégrant dans un écosystème riche d’opportunités et de ressources.
Accompagnement technique et scientifique
Le Biotech’InnLab accompagne le développement des innovations, depuis l’idéation jusqu’à la réalisation des premiers prototypes et la validation de leur faisabilité technique, en offrant un soutien scientifique et technique adapté aux besoins des porteurs de projet. En s’appuyant sur les compétences des unités d’AgroParisTech, notamment, l’Unité de R&D Agro Biotechnologies Industrielles, cet accompagnement peut être ponctuel ou s’inscrire dans un temps plus long via un contrat de collaboration de recherche. Par ailleurs, les porteurs de projet bénéficient d’un accès privilégié à l’écosystème d’innovation d’AgroParisTech.
Une mise à disposition d’équipements multiples pour prototyper votre idée
Le Biotech’InnLab vous permet de concrétiser vos idées grâce à des équipements de pointe pour vos expérimentations. Vous aurez accès à des laboratoires spécialisés en microbiologie, enzymologie, fermentation en milieux liquides et solides, génie des procédés séparatifs, procédés d’éco-extraction et chimie verte, ainsi qu’à une plateforme analytique de pointe. Si nécessaire, une formation à l’utilisation de ces équipements vous sera proposée pour accompagner vos recherches et essais.
Les équipements des laboratoires permettent de :
- Produire
- Extraire, séparer, purifier
- Qualifier et quantifier
- Fonctionnaliser
Ces matériels sont accessibles à l’ensemble des incubés du Biotech’InnLab sous réserve de leur disponibilité et d’une formation adéquate proposée par les chercheurs de l’URD ABI.
Une implantation au cœur de l’innovation
Situé au sein du Centre Européen de Biotechnologie et de Bioéconomie (CEBB), sur la bioraffinerie de Bazancourt-Pomacle et sur le site AgroParisTech de Reims, vous intégrerez un écosystème dynamique et innovant résolument tourner vers la bioéconomie et vous aurez l’opportunité de discuter et d’interagir avec différents acteurs engagés au niveau local (académiques, industriels, start-ups, collectivités, coopératives…).
Hébergement et accueil
L’hébergement au Biotech’InnLab comprend :
- Une halle technologique avec un espace dédié permettant une première montée en échelle (e.g. de la plaque 96 puits au bioréacteur de 20 L en passant par des colonnes de fermentation en milieu solide et des fermenteurs liquides de 1 et 5 L) ;
- Une plateforme de chimie analytique (HPLC, GCMS, LCMS, RMN, DSC, TGA…) ;
- Une plateforme d’éco-extraction (Pilote de filtration, CO2 supercritique, Broyeur à bille, ultra-son, ASE (extraction accélérée par solvant) ;
- Des laboratoires de chimie verte avec des équipements de pointe ainsi qu’une zone scale-up permettant la production de molécules à l’échelle du kilo (réacteur 5 L & 10 L) ;
- Des espaces collaboratifs : bureaux collectifs, salles de réunion ou de visio-conférence ;
- Des espaces de conférence ;
- Des espaces de convivialité.
Intégrer le Biotech’InnLab, c’est aussi intégrer un réseau :
- Accéder et bénéficier de mises en relations au sein de l’écosystème d’AgroParisTech : Unités de Recherche, enseignants-chercheurs, Fondation AgroParisTech, AgroParisTech Innovation, Junior Entreprise (ASE), réseau d’étudiants, etc. ;
- Rejoindre le large réseau de partenaires d’AgroParisTech et des InnLabs avec des expertises notamment sur l’accompagnement et le financement de l’innovation et de l’entrepreneuriat ;
- Bénéficier d’un suivi personnalisé des projets ;
- Avoir un accès privilégié aux autres InnLabs et à leurs expertises ;
- Accéder aux ressources documentaires d’AgroParisTech et à ses abonnements (veille, articles scientifiques, études xerfi, etc.) ;
- Profiter de masterclass thématique organisées pour les entrepreneurs de l’écosystème, sur des expertises complémentaires à celles proposées dans les InnLabs (réglementation, propriété intellectuelle, financement, recrutement, industrialisation, etc.) ;
- Disposer d’un accès privilégié aux événements organisés par AgroParisTech et ses partenaires ;
- Intégrer la mailing list des porteurs de projet accompagnées au Biotech’InnLab avec partage des actualités sur l’entrepreneuriat et des évènements phares ;
- Échanger avec l’équipe Innovation pour aider à cadrer et déterminer les besoins futurs et soulever de nouvelles questions.